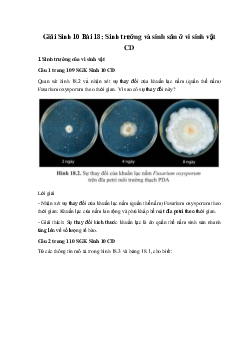
Giải Sinh 10 Bài 18: Sinh trưởng và sinh sản ở vi sinh vật | Cánh diều

Chủ đề 9: Sinh học vi sinh vật (CD)
Danh sách Tài liệu
-
Giải Sinh học 10 Bài 20: Thành tựu của công nghệ vi sinh vật và ứng dụng của vi sinh vật | Cánh diều
527 264 lượt tải 4 trangGiải bài tập Sinh 10 Bài 20: Thành tựu của công nghệ vi sinh vật và ứng dụng của vi sinh vật sách Cánh diều giúp các em học sinh lớp 10 hiểu được kiến thức về các thành tựu đạt được của công nghệ vi sinh vật. Đồng thời biết cách trả lời được các bài tập Sinh 10 trang 123 →130.
Môn: Sinh học 10Chủ đề: Chủ đề 9: Sinh học vi sinh vật (CD)Dạng: Lý thuyết, Đáp ánTác giả: VietJack1 năm trước -
Giải Sinh học 10 Bài 19: Quá trình tổng hợp phân giải ở vi sinh vật và ứng dụng | Cánh diều
340 170 lượt tải 3 trangGiải Sinh 10 Bài 19 Cánh diều là tài liệu vô cùng hữu ích dành cho giáo viên và các em học sinh tham khảo, đối chiếu với lời giải hay, chính xác nhằm nâng cao kết quả học tập của các em. Vậy sau đây là nội dung chi tiết soạn Sinh 10 Bài 19: Quá trình tổng hợp phân giải ở vi sinh vật và ứng dụng, mời các bạn cùng theo dõi và tải tại đây.
Môn: Sinh học 10Chủ đề: Chủ đề 9: Sinh học vi sinh vật (CD)Dạng: Lý thuyết, Đáp ánTác giả: VietJack1 năm trước -
Giải Sinh học 10 Bài 18: Sinh trưởng và sinh sản ở vi sinh vật | Cánh diều
339 170 lượt tải 4 trangGiải Sinh 10 Bài 18 Cánh diều là tài liệu vô cùng hữu ích dành cho giáo viên và các em học sinh tham khảo, đối chiếu với lời giải hay, chính xác nhằm nâng cao kết quả học tập của các em. Vậy sau đây là nội dung chi tiết soạn Sinh 10 Bài 18: Sinh trưởng và sinh sản ở vi sinh vật, mời các bạn cùng theo dõi và tải tại đây.
Môn: Sinh học 10Chủ đề: Chủ đề 9: Sinh học vi sinh vật (CD)Dạng: Lý thuyết, Đáp ánTác giả: VietJack1 năm trước -
Giải Sinh học 10 Bài 17: Vi sinh vật và các phương pháp nghiên cứu vi sinh vật | Cánh diều
359 180 lượt tải 3 trangGiải Sinh 10 Bài 17 Cánh diều là tài liệu vô cùng hữu ích dành cho giáo viên và các em học sinh tham khảo, đối chiếu với lời giải hay, chính xác nhằm nâng cao kết quả học tập của các em. Vậy sau đây là nội dung chi tiết soạn Sinh 10 Bài 17: Vi sinh vật và các phương pháp nghiên cứu vi sinh vật, mời các bạn cùng theo dõi và tải tại đây.
Môn: Sinh học 10Chủ đề: Chủ đề 9: Sinh học vi sinh vật (CD)Dạng: Lý thuyết, Đáp ánTác giả: VietJack1 năm trước -
Giải Sinh 10 Bài 20: Thành tựu của công nghệ vi sinh vật và ứng dụng của vi sinh vật | Cánh diều
524 262 lượt tải 7 trangXin gửi tới bạn đọc bài viết Giải Sinh 10 Bài 20: Thành tựu của công nghệ vi sinh vật và ứng dụng của vi sinh vật CD. Mời bạn đọc cùng tham khảo chi tiết bài viết dưới đây nhé.
Môn: Sinh học 10Chủ đề: Chủ đề 9: Sinh học vi sinh vật (CD)Dạng: Đáp ánTác giả: VietJack1 năm trước -
Giải Sinh 10 Bài 19: Quá trình tổng hợp phân giải ở vi sinh vật và ứng dụng | Cánh diều
350 175 lượt tải 4 trangGiải Sinh 10 Bài 19: Quá trình tổng hợp phân giải ở vi sinh vật và ứng dụng CD được sưu tầm và xin gửi tới bạn đọc cùng tham khảo. Mời các bạn cùng theo dõi chi tiết bài viết dưới đây nhé.
Môn: Sinh học 10Chủ đề: Chủ đề 9: Sinh học vi sinh vật (CD)Dạng: Đáp ánTác giả: VietJack1 năm trước -
Giải Sinh 10 Bài 18: Sinh trưởng và sinh sản ở vi sinh vật | Cánh diều
310 155 lượt tải 7 trangGiải Sinh 10 Bài 18: Sinh trưởng và sinh sản ở vi sinh vật CD được sưu tầm và xin gửi tới bạn đọc. Mời các bạn cùng theo dõi chi tiết bài viết dưới đây nhé.
Môn: Sinh học 10Chủ đề: Chủ đề 9: Sinh học vi sinh vật (CD)Dạng: Đáp ánTác giả: VietJack1 năm trước -
Giải Sinh 10 Bài 17: Vi sinh vật và các phương pháp nghiên cứu vi sinh vật | Cánh diều
354 177 lượt tải 4 trangGiải Sinh 10 Bài 17: Vi sinh vật và các phương pháp nghiên cứu vi sinh vật CD được tổng hợp và xin gửi tới bạn đọc. Mời các bạn cùng tham khảo chi tiết.
Môn: Sinh học 10Chủ đề: Chủ đề 9: Sinh học vi sinh vật (CD)Dạng: Đáp ánTác giả: VietJack1 năm trước